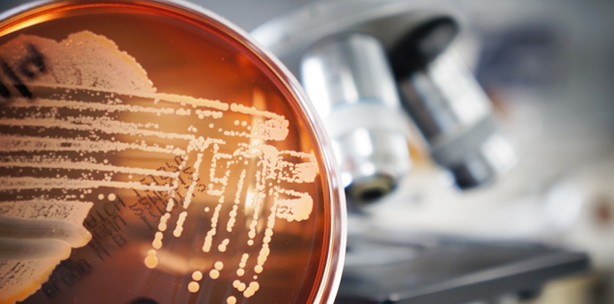
Neue Erkenntnisse über die Entstehung von Biofilmen

Wissenschaft und Forschung 25.04.2013
Neue Erkenntnisse über die Entstehung von Biofilmen
Biofilme entstehen, wenn sich Bakterienkolonien unter einer resistenten Schleimschicht gegen äußere Einflüsse schützen. Was aber die Kolonien veranlasst, einen Biofilm zu bilden, haben Forscher der Newcastle University genauer untersucht. Dabei beobachteten sie die Interaktion des Proteins SinR mit anderen Proteinen während es an die DNA gebunden ist und auch, während es das nicht ist.
Biofilme sind zähe Schleimstrukturen, unter denen Bakterienkolonien sich gegen ihre Feinde schützen. Sie können Zahnbelag und diverse Entzündungen verursachen, sowie an Implantaten zu lebensbedrohlichen Infektionen führen. Die Forscher untersuchten die Biofilmbildung des Heubazillus (Bacillus subtilis), um die Ursache für dessen Entstehungsmechanismus zu ergründen.
Das Protein SinR ist der Hauptregulator für die Bildung von Biofilmen. Dieses Protein interagiert mit drei anderen Proteinen. Je nach Einfluss dieser ist es entweder an die DNA gebunden oder nicht. Richard Lewis, Professor am Institut für Zelluläre und Molekulare Biowissenschaft, vergleicht SinR mit einem simplen Kippschalter. Im Falle der Bindung von SinR an die DNA sind die anderen Proteine, die für die Bildung eines Biofilms notwendig sind, inaktiv. Die Bakterien können sich frei bewegen und bilden keine zusammenhängende Struktur. Wenn SinR aktiv wird, der Schalter also auf „an“ umgelegt wird, dann ist es von der DNA losgelöst und interagiert mit den anderen Proteinen. In diesem Fall bilden sie einen Biofilm. Die Eigenschaft von SinR sich an die DNA zu binden ist die Grundlage, dass andere Proteine daran gehindert werden, einen molekularen „Klebstoff“ zu bilden, der den Biofilm zusammenhält.
Aus der Erkenntniss, wie die Proteine aufeinander wirken und mit der DNA reagieren, können die Forscher die Grundlage zur Bildung neuer Moleküle gewinnen. Diese ermöglichen dann eventuell, in die Wechselwirkungen zwischen den Proteinen einzugreifen und somit die Bildung von Biofilmen zu verhindern.
Quelle: www.ncl.ac.uk